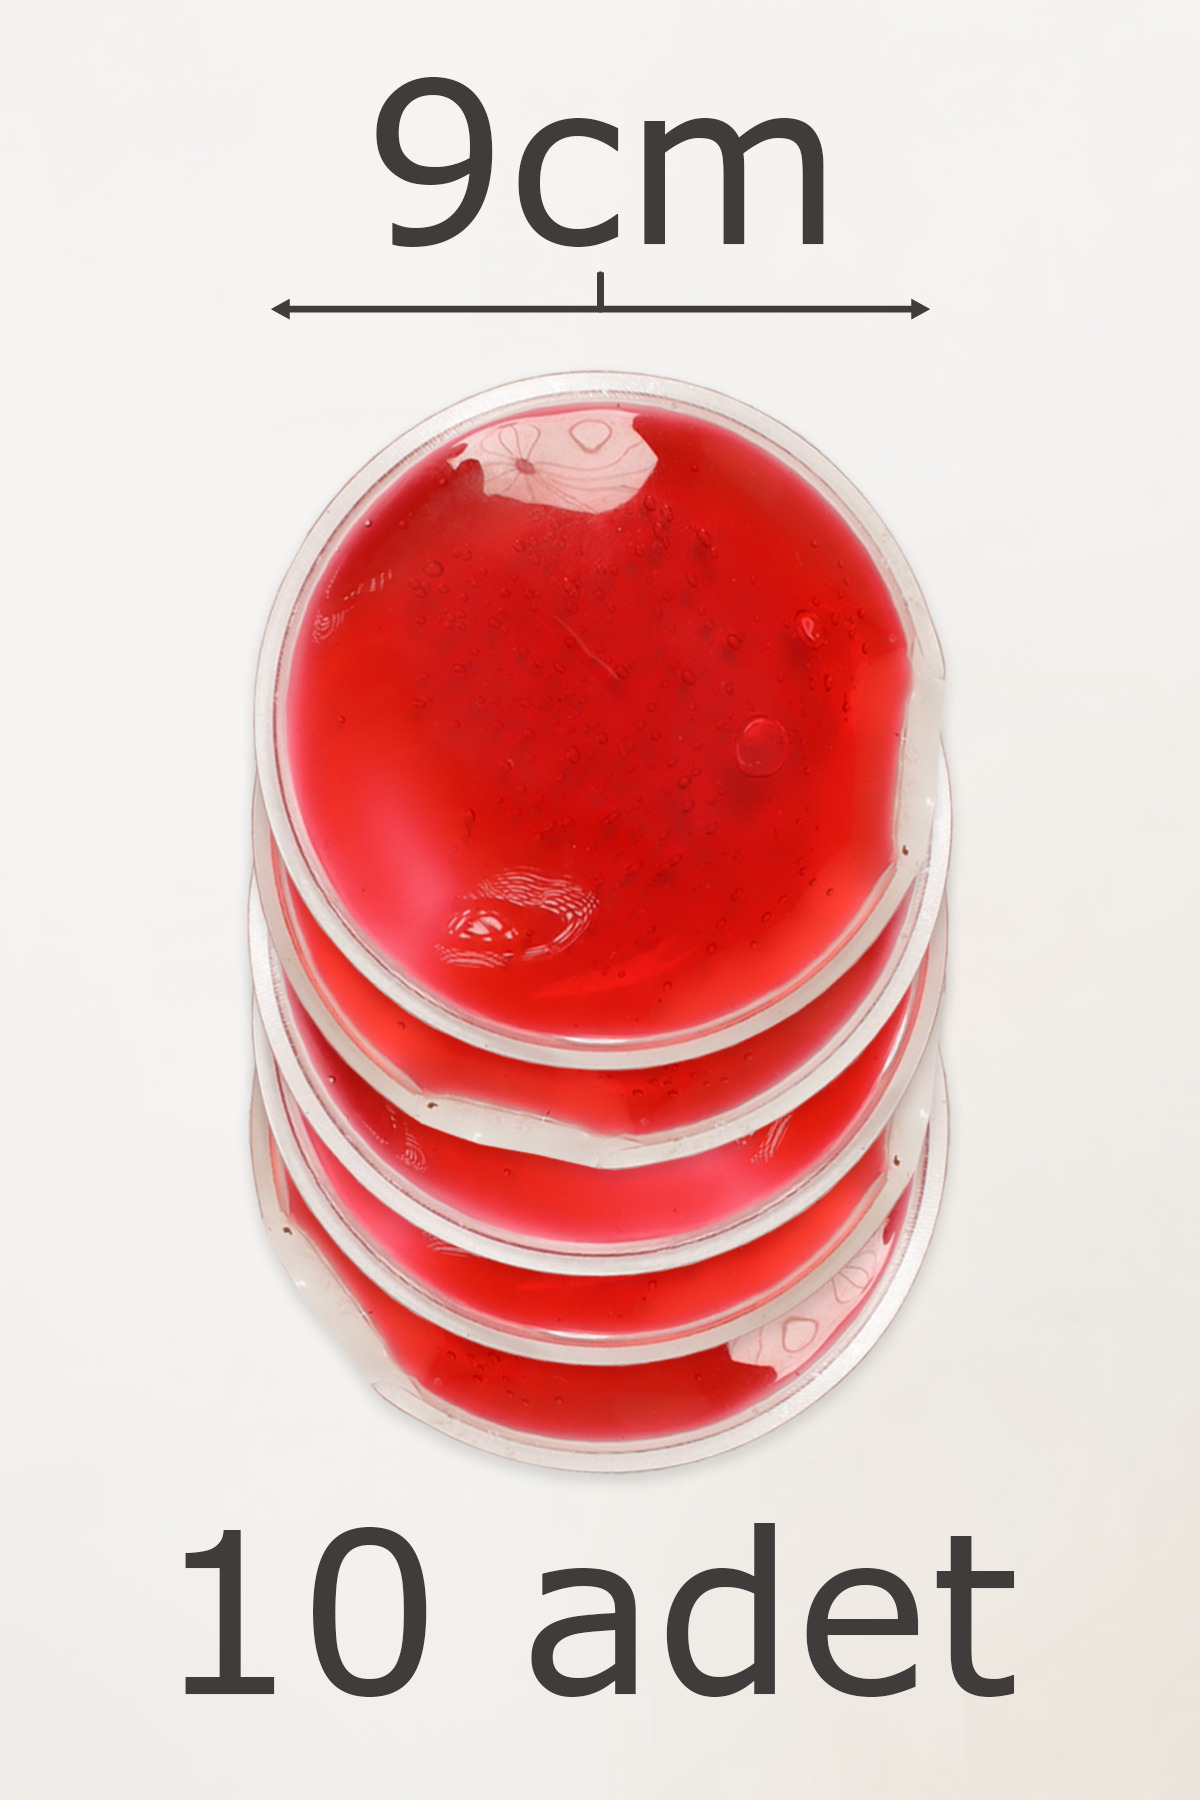

Göz Burun Estetiği Sonrası Tekrar Kullanılabilir Sıcak Soğuk Kompres Jel | 10’lu Yuvarlak Set Göz Burun Estetiği Sonrası Tekrar Kullanılabilir Sıcak Soğuk Kompres Jel | 10’lu Yuvarlak Set VNC-9144/10 تک سایز
- برند : vanaca-grup
انتخاب سایز:
- ویژگیهای محصول
- Menşei : TR
- Ürün Güvenliği Bilgisi : Tehlikeli Değil
سایت مرجع :
ترندیول
فروشنده:
Vanaca Grup
امتیاز فروشنده:
9.5
زمان تحویل در ترکبه:
5 روز
قیمت:
1,090,980تومان

 ورود | ثبت نام
ورود | ثبت نام

نظرات کاربران ترندیول